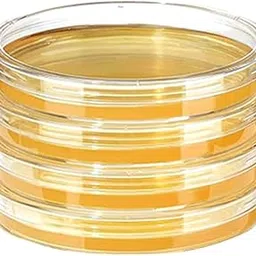

Compare 'inv home white ceramic circular ring' prices, check price history, find top deals at lowest prices.
Filter By Categories
Filter By Website
Filter By Price
₹119 - ₹109699+

+5
Myntra.com
₹852
THE QUIRKY HOME White & Blue Two Birds In Bloom Printed Ceramic Decorative Wall Decor

+5
Myntra.com
₹946
THE QUIRKY HOME White Horse Carriage In A European Village Printed Ceramic Wall Decor

+3
Amazon.in
₹199
Artificial Green White Flowers in White Ceramic Pot, Faux Floral Arrangement, Decorative Plant with Leaves for Home Decor

+5
Flipkart.com
₹249
ROUND TABLETOP ASHTRAY FOR HOME, OFFICE IN/OUT DOOR USE|HOME DÉCOR|PET FOOD POT White Ceramic, Crystal Ashtray

Amazon.in
₹229
Artificial Bonsai Tree with Pink Rose Flowers, Decorative Faux Plant in White Ceramic Pot, Japanese Style Indoor Home Decor

+5
Myntra.com
₹2398
THE QUIRKY HOME 3Pcs White & Blue Oceanic Echoes in Porcelain Printed Ceramic Wall Decors

+5
Myntra.com
₹2567
THE QUIRKY HOME 3-Pcs White & Blue Buddha in a Minimalist Printed Ceramic Wall Plates

+5
Amazon.in
₹999
DY SAAZ Snuggle Hollow Ceramic Vase Set of 2, Nordic Modern Boho ins Style Decorative Ceramic Aesthetic Flower Vase for Home Decor (Milky White W 6.3" X H 8.4")

+5
Myntra.com
₹3710
THE QUIRKY HOME 5 Pieces Blue & White Sailing Vessels in Silhouette Ceramic Wall Plates

Amazon.in
₹499
Kreative Homes Flowy Flora Ceramic Oil Dispenser with Lid | Oil Bottle for Kitchen, 1 Litres, Ink Blue and White

+4
Firstcry.com
₹190
Safe-O-Kid Straw With Accessories Helpful For Kids In Drinking Home Essential - White

Amazon.in
₹15999
Classic Wood and Craft Handmade White Wooden Rocking Chair with Comfort Seating for Adults/Relaxing Chair for Home in White Deco Finish

+5
Amazon.in
₹2599
STYLEHEAVEN Stereo Gaming Headsets Built in Mic Adjustable Headband for Pc Office Home White

Amazon.in
₹2621
CALANDIS™ Stereo Gaming Headsets Built in Mic Adjustable Headband for PC Office Home White | Headphones | Portable Audio & Headphones

+5
Amazon.in
₹949
4 in 1 Led Desk Lamp with Magnetic Wireless Rechargeable Table Lamps Adjustable 3 Brightness Eye Caring Sensitive Control Bedside Light Removable Ambiance Wall Lighting for Home (White)

+5
Amazon.in
₹1899
Cinidy 2 in 1 Facial Steamer and Hair Steamer Face Sauna Humidifier Hot Mist Moisturizing for For Cold and Cough Nose Facial SPA Skin Care Salon and home (white colorss) (whiites)

Amazon.in
₹599
PVC Adjustable Water Dispenser Base for All Models Hot/Cold Water Dispensers Useful in Home and Office, Pack of 1 White

+5
Tatacliq.com
₹3580
Mr. Butler Italia Soda Maker White - Single Cylinder, Create Sparkling Water In Home Kitchen

+5
Firstcry.com
₹909
Kids Station Baby Proofing Safety Kit 5m Edge Protector + 8 Corner Guards + 10 Safety Locks + 4 Door Stoppers All-in-One Baby Safety Kit for Home (White + Grey)

+5
Amazon.in
₹1599
Indian Decor 50110 Magazine Holder- Metal Magazine Rack Mail Organizer Folder Organizer Bin for Magazines, Books, Newspapers, Tablets in Home, Office- White

+5
Amazon.in
₹715
Rechargeable LED Table Light with Power Bank (5000mAh) – 3-Color Adjustable Handheld Desk Lamp, Eye Protection Table Lamp with Built-in Phone Holder for Kids Room, Office, Home (White)

+3
Amazon.in
₹144
Virgo Citric Acid, For Cleaning and Baking, Making beverages Multiple use in Home and Kitchen, Sour Taste, White Color, Pack of 1, 190gm

+4
Myntra.com
₹320
HOME COLORS.IN White & Black 2 Pcs Cotton Embroidered Square Cushion Covers

+5
Myntra.com
₹735
HOME COLORS.IN White Striped Cotton 8-Seater Table Cover with Embroidered details

+5
Myntra.com
₹885
HOME COLORS.IN White & Peach Colored Striped Cotton 8-Seater Table Cover

+5
Myntra.com
₹705
HOME COLORS.IN White & Blue Geometric Printed Cotton 6-Seater Table Cover

+5
Amazon.in
₹299
PLANT EXOTIC | Unique & Rare Ficus Bonsai Live Plant | Indoor Live Plants for Home, Table, Kitchen & Desk Decor | Real Indoor Bonsai Live Plants - in Beautiful White Ceramic Pot

+5
Myntra.com
₹946
THE QUIRKY HOME Love In The Rain White & Blue Printed Ceramic Wall Decor Plate

+5
Firstcry.com
₹909
Kids Station Baby Proofing Safety Kit 5m Edge Protector + 8 Corner Guards + 10 Safety Locks + 4 Door Stoppers All-in-One Baby Safety Kit for Home (White + White)

+5
Myntra.com
₹611

![[2020 Upgrade] Cable Concealer, PVC Cord Cover, 94.5in Paintable Cord Hider to Hide Wires for TV & Computers in Home Office 6X L15.75in W1.18in H0.67in, White CC02-image-62](https://pimg.cheapestinindia.com/product/1/ooo/_HH-/XXX/8/webp/256x256/UL320_OCL._AC_71UNoaLfmages/I/on.com/idia-amaz_HH-m.me.jpg)

























